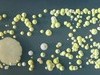

▲小佟用840個魔術方塊告白卻被拒絕。(圖/CFP)
大陸中心/綜合報導
你聽過什麼最特別的告白方式?大陸瀋陽一名年輕人為了追求愛慕的女孩,用了840個魔術方塊拼出女孩的照片,耗時3天才終於完成。可惜的是,照片中這名長髮清秀的女孩知道後,雖然感動,但仍沒有交往的意思,殘忍地拒絕了!
陸媒報導,這位有心人是27歲、念理工科的小佟,他從去年開始接觸魔術方塊,原本只是研究解法,但後來看到有人用魔術方塊來拼圖,於是自己就想到用這招來告白,他說:「這畫看起來挺簡單,做起來卻複雜!」
小佟分享製作過程,「在整張照片截下人臉然後放大,用Photoshop馬賽克化,之後逐格上色,大致分一下能有多少個色塊,而且還必須是3的整倍數。」他說前期設計完後,就上網花了2000多元人民幣買了900個魔術方塊,再買木板來手工打造、作畫。
小佟指出,必須按照草圖對應顏色,真的很困難,「剛開始拼不熟,一分鐘一個,後來30秒就能轉成我想要的顏色。」最後熬了3個晚上,才終於拼出這面高2.6公尺、寬1.37公尺的照片牆。其他人遠遠一看,就能知道拼出來的圖案是個長髮飄逸的清新女孩。
可惜結局並不如大家想的美好。小佟透露,自己在拼圖完成當天就興奮的跟對方告白了,女孩看過拼圖後很感動,但最後還是沒有接受他,留下遺憾。
►►看更多小佟做的魔術方塊女孩照片
★ 版權聲明:圖片為版權照片,由CFP視覺中國供《ET新聞雲》專用,任何網站、報刊、電視台未經CFP許可,不得部分或全部轉載,違者必究!

讀者迴響